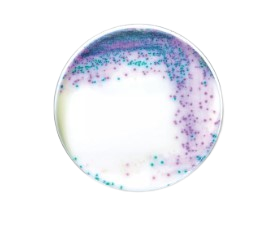

RAPID'Salmonella Medium
RAPID'Salmonella Medium is a sensitive chromogenic agar used for the detection and enumeration of Salmonella spp. in products that are intended for human and animal consumption, including swab enviromental and rectal.


RAPID'Salmonella Medium is a sensitive chromogenic agar used for the detection and enumeration of Salmonella spp. in products that are intended for human and animal consumption, including swab enviromental and rectal.
Principle
The high specificity and high selectivity of RAPID'Salmonella Medium are due to a combination of enzymatic activities (C8 esterase and β-D glucosidase) and the inhibition of contaminating food flora.
Features & Benefits
Theoretical Composition
| Nutritive mix | 14.5 g |
| Selective agents | 14 g |
| Chromogenic mix | 2.3 g |
| Agar | 12.7 g |
| Distilled water | qsp 1,000 ml |
| Final pH at 25°C = 7.2 ± 0.2 | |
Product Size
- #3564705 ; Dehydrated, 500 g
- #3563961 ; Ready to use plates, 90 mm x 20 dishes
Storage
Store dehydrated medium at 2-8 ⁰C in carefully sealed bottle in a dry and dark place
Store prepoured agar medium at 2-8 ⁰C in dark place
References
- ISO 6579-1:2017/AMD1:2020
- ISO 16140-2:2016